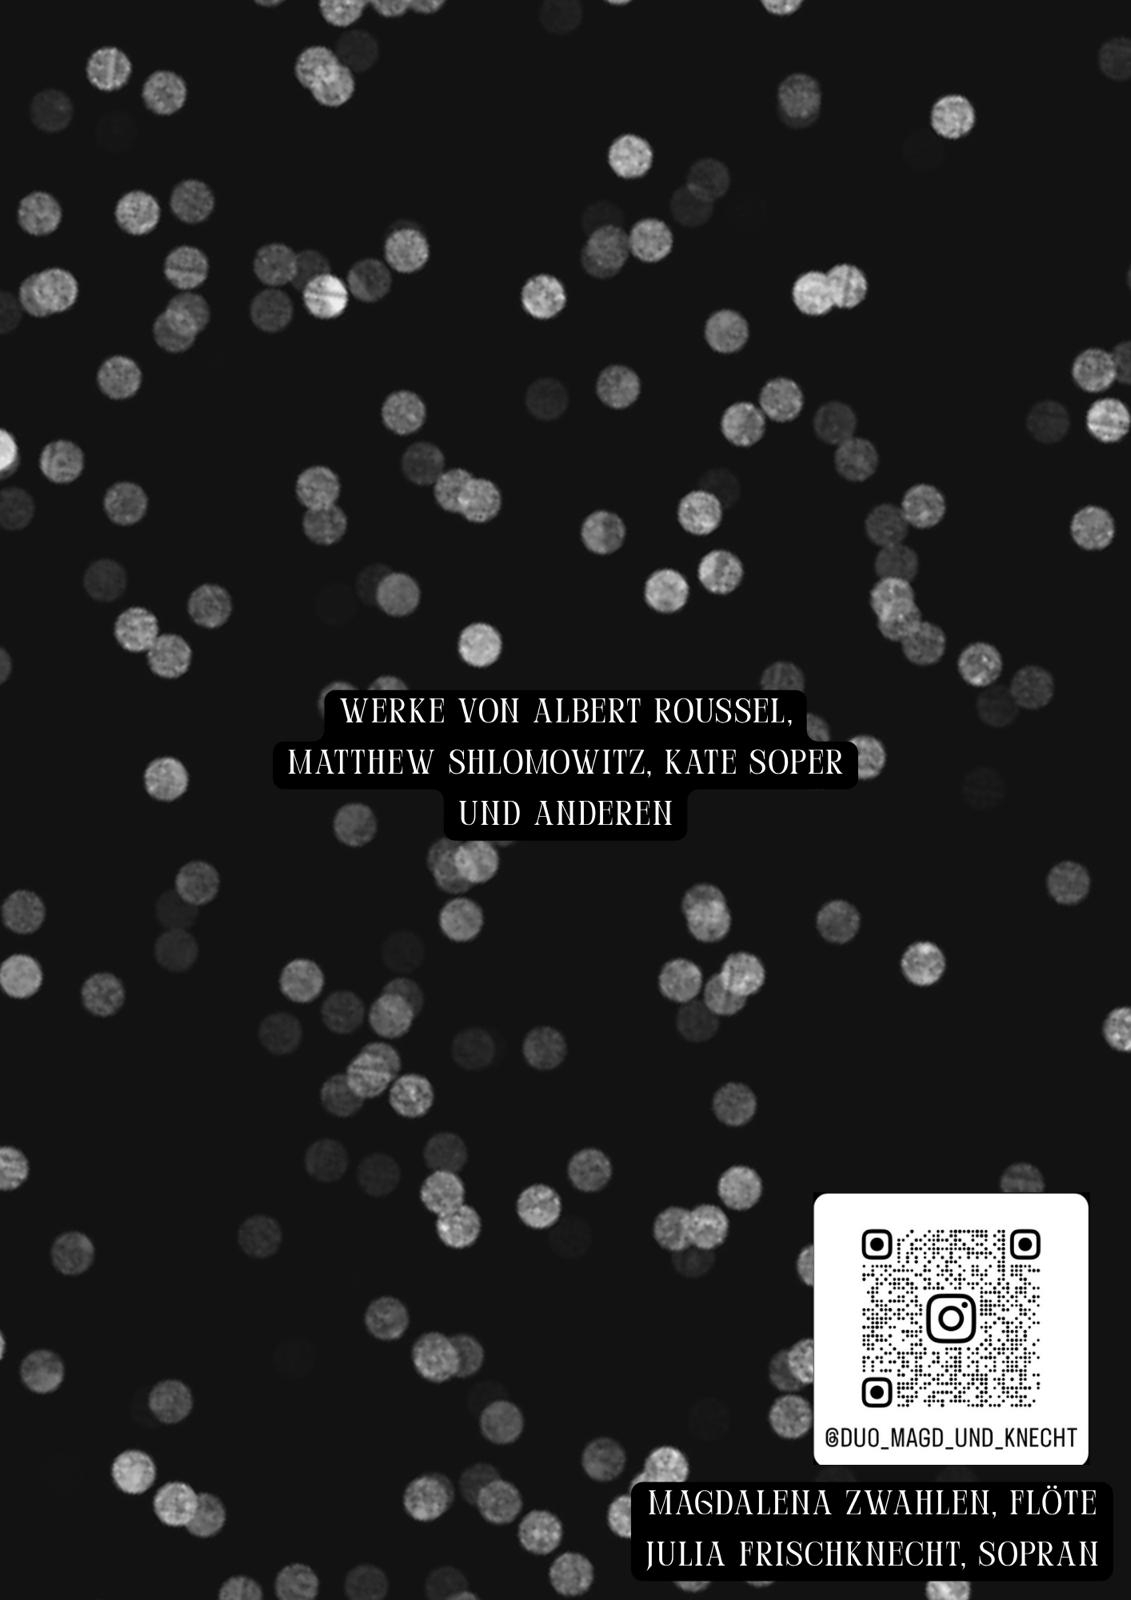

CIEL, AIR ET VENTS, DUO MAGD&KNECHT
Das Duo Magd & Knecht besteht aus der Flötistin Magdalena Zwahlen und der Sopranistin Julia Frischknecht. Die beiden Musikerinnen erkunden mit der ungewöhnlichen Kombination ihrer Instrumente gemeinsam neue musikalische Welten und verknüpfen mit viel Leichtigkeit Neues mit Altbekanntem.
Dabei treffen Volkslieder auf performative zeitgenössische Musik und klassische Musik wird neu interpretiert.
An der Mittelschule kennengelernt, haben sich die beiden Künstlerinnen im Studium wiedergetroffen und entfalten als Duo Magd & Knecht seither ihre kreativen Flügel.
Mit viel Enthusiasmus erarbeiten sie gemeinsam Konzertprogramme, die dank ihrer platzsparenden Instrumente für verschiedene Räumlichkeiten und Settings adaptiert werden können. Eine gute Prise Charme und Schalk muss man dabei auch nicht missen.
Werke von Albert Roussel, Kate Soper, Matthew Shlomowitz und anderen
Preis(e)
Organisation
- Duo Magd&Knecht